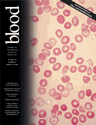

Abstract
Aggretin, a collagen-like α2β1 agonist purified from Calloselasma rhodostoma venom, was shown to increase human umbilical vein endothelial cell (HUVEC) proliferation and HUVEC migration toward immobilized aggretin was also increased. These effects were blocked by A2-IIE10, an antibody raised against integrin α2. Aggretin bound to HUVECs in a dose-dependent and saturable manner, which was specifically inhibited by A2-IIE10, as examined by flow cytometry. Aggretin elicited significant angiogenic effects in both in vivo and in vitro angiogenesis assays, and incubation of HUVECs with aggretin activated phosphatidylinositol 3-kinase (PI3K), Akt, and extracellular-regulated kinase 1/2 (ERK1/2); these effects were blocked by A2-IIE10 or vascular endothelial growth factor (VEGF) monoclonal antibody (mAb). The angiogenic effect induced by aggretin may be via the production of VEGF because the VEGF level was elevated and VEGF mAb pretreatment inhibited Akt/ERK1/2 activation as well as the in vivo angiogenesis induced by aggretin. The VEGF production induced by aggretin can be blocked by A2-IIE10 mAb pretreatment. In conclusion, aggretin induces endothelial cell proliferation, migration, and angiogenesis by interacting with integrin α2β1, leading to activation of PI3K, Akt, and ERK1/2 pathways, and the increased expression of VEGF may be responsible for its angiogenic activity.
Introduction
Angiogenesis, the formation of new capillaries from preexisting blood vessels, plays an important role in physiologic and pathologic processes, such as the embryonic development, wound healing, tumor growth, metastasis, and various inflammatory disorders.1 All forms of angiogenesis are thought to share certain basic features, including migration and mitogenesis of endothelial cells, lumen formation, connection of new vascular segments with the preexisting circulation, and extensive remodeling of the extracellular matrix (ECM) by proteases. Interactions between endothelial cells and ECMs including fibrinogen, vitronectin, collagen, laminin, and von Willebrand factor (VWF), through cell surface adhesion receptors, are involved in the multiprocesses of neovascularization.2 Both β13-5 and αv integrins6 have been implicated in angiogenesis. For example, integrin αvβ3 is not readily detectable in quiescent vessels but becomes highly expressed in angiogenic vessels.7 The dependency of angiogenesis on vascular cell adhesion events in vivo is evidenced by the observation that antibody and snake venom proteins antagonizing integrin αvβ3 blocked angiogenesis in the chick chorioallantoic membrane (CAM) model.8,9 On the other hand, Lian et al10 assumed that endothelial glycoprotein Ib (GPIb) may help to mediate the process of endothelial cell migration during wound repair in vivo, and snake venom protein agkistin, a GPIb antagonist, was reported to block angiogenesis.11
Although the molecular mechanisms of action responsible for regulating survival of migratory cells are not well established, adhesive proteins present in the ECMs are likely to play a central role.12,13 In fact, the collagen-rich environment of ECMs is one of the first barriers that a migratory cell encounters during invasion.14 Integrin α2β1 is a major collagen receptor both on endothelial cells and platelets. In cells expressing integrin α2β1, many signals including the extracellular-regulated kinase (ERK) pathway and matrix remodeling were activated after cell adhesion to collagen.15,16 Also, α2β1 integrin has been implicated in endothelial cell proliferation,3 cell survival,17 and tube formation of endothelial cells.4 Thus the previously reported functions of integrin α2β1 raise the possibility of playing an important role in angiogenesis.
Vascular endothelial growth factor (VEGF),18 an angiogenic cytokine, functions as a survival factor for endothelial cells in vivo and in vitro.19,20 It is well established that VEGF and its receptors are important mediators during different steps of angiogenesis.21 It was previously shown that VEGF activated various signal transducers including the phosphatidylinositol 3-kinase (PI3K)/Akt and ERK signaling pathway.22-25 Akt and ERK are important regulators of various cellular processes including cell survival and migration.26,27 The information summarized suggests a similarity or overlap in the functional responses of cells to engagement of VEGF/VEGF receptors and extracellular matrix/integrin systems during angiogenesis. Mechanisms for direct communication between VEGF and integrins remain undefined and may reflect a convergence of their downstream intracellular signaling pathways.28
Snake venoms contain many unique components that affect cell-matrix interaction. Some venom proteins have been identified as heterodimeric C-type lectinlike proteins. These heterodimers affect platelet aggregation by interacting with platelet GPIb, GPVI, or integrin α2β1. Aggretin, a potent platelet-aggregating protein purified from Calloselasma rhodostoma venom, consists of α and β subunits that share homologous sequences to those of the C-type lectins.29 In previous studies, we have demonstrated that PI3K was phosphorylated during its platelet-activating process.30,31 PI3K has been implicated in regulating cell proliferation, survival, metabolism, and cytoskeletal organization.32 Moreover, a monoclonal antibody (mAb) A2-IIE10 raised against α2 integrin in combination with agkistin, a snake venom–derived GPIb antagonist,33 completely abolished aggretin-induced platelet aggregation, indicating that aggretin activates platelets most likely via GPIb and integrin α2β1 receptors.31 In the present study, we unveiled the angiogenic activities of aggretin, including promotion of human umbilical vein endothelial cell (HUVEC) proliferation, migration, and Matrigel-induced capillary tube formation in vitro, and induction of neovascularization in a chick CAM angiogenesis model in vivo. The possible target sites of aggretin on HUVECs and the signaling pathways involved in angiogenesis elicited by aggretin were also examined.
Materials and methods
Materials
Aggretin and agkistin was purified from Calloselasma rhodostoma and Formosan Agkistrodon acutus venom, respectively, as previously described.30,31 Protein A/G plus-Sepharose, peroxidase-conjugated antimouse and antirabbit antibodies, anti-PI3K p85α polyclonal antibody (Z-8), antiphospho-ERK1/2 (E-4), and enhanced chemiluminescence (ECL) detection system were purchased from Santa Cruz Biotechnology (Santa Cruz, CA). Anti-α2 mAb (A2-IIE10), peroxidase-conjugated antisheep antibody, antiphospho-Akt1 (Ser473), and antiphosphotyrosine mAb (4G10) were from Upstate Biotechnology (Lake Placid, NY). Anti–α-tubulin mAb (Ab-1) was from Oncogene Research (Cambridge, MA). Fluorescein-5-isothiocyanate (FITC) was from Molecular Probes (Eugene, OR). 3-[4,5-Dimethylthiazol-2-yl]-2,5-diphenyltetrazolium bromide (MTT), toluidine blue O, collagen type I, bovine serum albumin (BSA), LY294002, and PD98059 were from Sigma (St Louis, MO). Medium 199 (M199), fetal bovine serum (FBS), and all cultured reagents were purchased from Gibco (Grand Island, NY). Endothelial cell growth supplement (ECGS) was from Upstate Biotechnology. Recombinant human VEGF and VEGF mAb were purchased from R&D Systems (Minneapolis, MN).
Cell culture
HUVECs were prepared as previously described.34 Umbilical cord veins were cannulated and flushed with cord buffer to remove blood and then filled with 0.1% collagenase (type I) for 10 minutes at 37°C. Isolated endothelial cells, identified as positively immunofluorescent staining for VWF antigen (Dako, Carpinteria, CA), were maintained in M199 containing 20% FBS, 30 μg/mL ECGS, 4 mM l-glutamine, 100 U/mL penicillin, and 100 μg/mL streptomycin, and incubated at 37°C in 5% CO2. The cells were used between the second to fourth passages.
Cell proliferation
HUVECs (2 × 104 cells/well) were seeded to 24-well plates (Costar, Corning, NY) for attachment, and cells were grown in serum-free M199 in absence or presence of various concentrations of aggretin for 48 hours before MTT assay. The inhibitory compounds were added as indicated. For MTT assay, cells were incubated with MTT at a final concentration of 0.5 mg/mL for 4 hours. After incubation, the medium was aspirated, and the cells were dissolved in dimethyl sulfoxide, and then the developed color absorbance at 550 nm was measured. For control, HUVECs were grown in M199 with or without 20% FBS for 48 hours and then assayed for cell proliferation.
Migration assay (haptotaxis)
HUVEC migration assay was performed using modified Boyden chamber model (Transwell apparatus, 8.0 μm pore size; Costar) as previously described with minor modification.35 The lower face of polycarbonate filters (Transwell inserts) was coated with aggretin (0.6 μg), collagen (0.2 μg), or BSA (20 μg) overnight, and the lower chamber was filled with 0.6 mL M199. HUVECs (5 × 104 cells/mL, 200 μL) were plated to the upper chamber of the Transwell in the absence or presence of A2-IIE10 (25 μg/mL) pretreatment for 30 minutes. After 16 hours of incubation, all nonmigrant cells were removed from the upper face of the Transwell membrane with a cotton swab, and the migrant cells were fixed and stained with 0.5% toluidine blue in 4% paraformaldehyde. Migration was quantified by counting the number of stained cells per × 100 field with an inverted contrast phase microscope (Nikon, Tokyo, Japan) and photographed.
Matrigel capillary tube formation
This assay was carried out by the method as previously described.36 Matrigel, a basement membrane matrix extracted from Engelbreth-Holm-Swarm mouse sarcoma (Becton Dickinson, Mountain View, CA), was diluted to 4 mg/mL with cold phosphate-buffered saline (PBS) and added to 24-well plates (Costar) in a total volume of 200 μL in each well. Plates were stood at 37°C for 30 minutes to form a gel layer. After gel formation, HUVECs (2 × 105 cells) in serum-free M199, in the presence of various concentrations of aggretin or 1% BSA, were applied to each well, and plates were incubated at 37°C for 24 hours with 5% CO2. The inhibitory compounds were added as indicated. After incubation, cells were washed, fixed in 2% glutaraldehyde for 10 minutes, subjected to inverted contrast phase microscope (Nikon) for observation and photographed.
Chick CAM angiogenesis assay
Eggs of 10-day-old chick embryos were opened with a 1.0-cm2 window that allowed direct access to underlying CAM by the method as previously described.37 Filter paper disk (13 mm, Minipore, Bedford, MA) saturated with VEGF (200 ng/disk) or aggretin (60 ng/disk) in the presence of test compounds or an equal aliquot of buffer (final in 20 μL) was applied to the top of the CAM. Inhibitory compounds were added as indicated. After 48 hours of incubation, CAM tissues under disks were resected and photographed by a digital camera (Nikon).
Binding assays of aggretin toward HUVECs
Flow cytometric studies were performed to assay the binding reaction and target receptor of aggretin toward HUVECs. HUVECs were suspended in PBS/1% BSA and fixed with 1% paraglutaraldehyde at 4°C for 30 minutes. Following washing with PBS/1%BSA, the cells were pretreated with A2-IIE10, agkistin, or 7E3 at 4°C for 1 hour in the presence of 5 mM CaCl2. Treated cells were washed twice and then incubated with FITC-conjugated aggretin for 30 minutes at 4°C for 1 hour with continuous shaking. After incubation, cells were washed twice, resuspended in PBS, and analyzed immediately by FACScalibur (Becton Dickinson) at excitation and emission wavelengths of 488 and 525 nm, respectively. Fluorescence signals from 10 000 cells were collected to calculate mean fluorescence intensity of a single cell and the percentage of positively staining cells.
Immunoprecipitation and Western blotting
HUVECs were pretreated with the various concentrations of aggretin for different time intervals and then lysed with lysis buffer (15 mM Tris [tris(hydroxymethyl)aminomethane]–HCl, 50 mM NaCl, 5 mM EGTA [ethyleneglycoltetraacetic acid], 1% Triton X-100, 1% sodium deoxycholate, 0.1% sodium dodecyl sulfate [SDS], 1 mM NaF, 1 mM phenylmethylsulfonyl fluoride [PMSF], 1 mM Na3VO4, 10 μg/mL aprotinin, and 10 μg/mL leupeptin, pH 7.4). After sonication of cells, the supernatant was isolated by centrifugation. PI3K p85α was immunoprecipitated from the supernatant using anti-PI3K p85α (Z-8) antibodies for 1 hour, then protein A/G PLUS-Sepharose was added for 1 hour. The pelleted protein A/G plus Sepharose was washed 3 times with 1 mL Tris-saline buffer and eluted with Laemmli SDS reducing buffer. The immunoprecipitates or HUVEC lysates were separated by SDS–polyacrylamide gel electrophoresis (SDS-PAGE) using 8% gels and transferred to polyvinylidene difluoride membranes. The membranes were blocked in 5% (wt/vol) nonfat milk dissolved in Tris/phosphate/saline/Tween and incubated with primary and secondary antibodies, which were diluted in Tris/phosphate/saline/Tween containing 1% nonfat milk. Blots were washed for at least 1 hour in Tris/phosphate/saline/Tween. After each incubation with antibodies, membranes were developed using an enhanced chemiluminescence (ECL) detection system. Primary antibodies and horseradish peroxidase–conjugated secondary antibodies were used at a concentration of 1 μg/mL.
Quantification of VEGF levels
HUVECs were pretreated with the various concentrations of aggretin for different time intervals. HUVECs and the serum-free M199 media bathing the cells were collected. VEGF concentrations of cell lysates and conditioning medium were determined as described by the manufacturer's instruction using a quantitative enzyme-linked immunosorbent assay (ELISA; Assay Designs, Inc., Ann Arbor, MI). All analyses and calibrations were carried out in triplicate. VEGF immunoreactivity was determined as compared to recombinant human VEGF standards. Optical densities were determined at 450 nm using a microtiter plate spectrophotometer.
Results
Effect of aggretin on HUVEC proliferation and migration
The processes of angiogenesis are complex, typically consisting of proliferation and alignment to form tubular structures.38 Collagen is the major constituent of the ECMs to which proliferating endothelial cells are exposed in an injured tissue,39 and Feng et al40 indicated that GPIb complex expressed on Chinese hamster ovary cells regulated cell proliferation. Thus, it is interesting to investigate whether the ligation of α2β1 or GPIb affects the viability of primary endothelial cells. Therefore, a HUVEC proliferation assay was performed by determining the cell metabolic activity with MTT. As shown in Figure 1A, aggretin dose dependently increased cell proliferation, and the activity of aggretin-induced HUVEC proliferation was partially inhibited by integrin α2β1 mAb, A2-IIE10 (25 μg/mL, about 60%), and completely blocked by a PI3K inhibitor, LY294002 (10 μM), or an ERK inhibitor, PD98059 (30 μM), as compared with control. These results suggest that aggretin–endothelial cell interaction is sufficient to promote cell proliferation, and this effect is mediated by integrin α2β1, and the activation of PI3K and ERK is involved in the proliferating signals induced by aggretin.
Effect of aggretin on HUVEC proliferation and migration. (A) HUVECs (4 × 104/mL) were seeded on 24-well plates. After attachment, cells were treated with indicated concentration of aggretin or aggretin in combination with PD98059 (30 μM), LY294002 (10 μM), or anti–integrin α2 mAb, A2-IIE10 (50 μg/mL), for 48 hours and then assayed by MTT. Results are expressed as fold of cell proliferation compared to control cells in the absence of serum (M199). Data are presented as mean ± SEM (n = 4). *P < .05 as compared with control (M199). (B) HUVECs (5 × 104/mL) incubated with or without anti–integrin α2 mAb, A2-IIE10 (AII, 25 μg/ml), were placed in the upper chamber of Transwell containing a gelatin-coated filter membrane. Haptotaxis was conducted by using a collagen-(col, 0.2 μg), aggretin-(agg, 0.6 μg), or BSA-coated (20 μg) filter for 16 hours. After fixation and removal of the nonmigrated cells of the upper filter, cells that migrated to the lower filter membrane were quantified by phase-contrast light microscopy under high-power field (HPF; original magnification × 100). All experiments were conducted in triplicate at least 4 times and similar results were obtained. Data are presented as mean ± SEM (n = 4-5). *P < .05 as compared with the respective control.
Effect of aggretin on HUVEC proliferation and migration. (A) HUVECs (4 × 104/mL) were seeded on 24-well plates. After attachment, cells were treated with indicated concentration of aggretin or aggretin in combination with PD98059 (30 μM), LY294002 (10 μM), or anti–integrin α2 mAb, A2-IIE10 (50 μg/mL), for 48 hours and then assayed by MTT. Results are expressed as fold of cell proliferation compared to control cells in the absence of serum (M199). Data are presented as mean ± SEM (n = 4). *P < .05 as compared with control (M199). (B) HUVECs (5 × 104/mL) incubated with or without anti–integrin α2 mAb, A2-IIE10 (AII, 25 μg/ml), were placed in the upper chamber of Transwell containing a gelatin-coated filter membrane. Haptotaxis was conducted by using a collagen-(col, 0.2 μg), aggretin-(agg, 0.6 μg), or BSA-coated (20 μg) filter for 16 hours. After fixation and removal of the nonmigrated cells of the upper filter, cells that migrated to the lower filter membrane were quantified by phase-contrast light microscopy under high-power field (HPF; original magnification × 100). All experiments were conducted in triplicate at least 4 times and similar results were obtained. Data are presented as mean ± SEM (n = 4-5). *P < .05 as compared with the respective control.
Endothelial migration is essential during the angiogenic process. In a haptotactic migration assay, as shown in Figure 1B, only a few control cells (BSA-coated insert) were found in the lower chamber after 16 hours of incubation, whereas a 10-fold increment of the migrated cells could be detected if aggretin was coated on the lower surface of filter membrane as a haptotaxic agent. HUVECs also migrated through a collagen-coated insert, exhibiting an even more profound effect. It was noted that the α2β1 mAb, A2-IIE10 (25 μg/mL), inhibited both aggretin- and collagen-induced cell migration by 56% and 60%, respectively, indicating that aggretin as well as collagen activate integrin α2β1 in promoting cell migration.
Effect of aggretin on Matrigel-induced tube formation and angiogenesis in the CAM model
To test the ability of aggretin to induce endothelial cell capillary tube formation, a Matrigel model was used in this study. When HUVECs are cultured on Matrigel, a solid gel of mouse basement membrane proteins, they easily align and form hollow tubelike structures.41 As shown in Figure 2Ai, when HUVECs were plated on Matrigel in serum-free medium, there was no tube formation. By contrast, VEGF caused a dramatic morphogenetic effect (Figure 2Aiv), and aggretin also caused endothelial tube formation in a dose-dependent manner (0.1 and 0.3 μM, respectively; Figure 2Aii-iii), compared with that of control (in serum-free M199; Figure 2Ai), and its angiogenic effect was blocked by integrin α2β1 mAb, A2-IIE10 (50 μg/mL; Figure 2Av).
Effect of aggretin on Matrigel capillary tube formation and angiogenesis in the chick CAM model. (A) HUVECs (2 × 105/well) were treated either in the absence (PBS control, i) or in the presence of VEGF (30 ng/mL, iv); in the presence of aggretin (0.1 μM, ii; or 0.3 μM, iii); or preincubated with anti–integrin α2 mAb, A2-IIE10, for 30 minutes, then treated in presence of aggretin (0.1 μM, v), and then plated on diluted Matrigel (4 mg/mL) for 24 hours. After washing and fixation, cells were observed under microscope at × 40 magnification and photographed. A representative one of 4 similar experiments is shown. (B) CAMs of 10-day-old chick embryos were incubated with vehicle (PBS, i), VEGF (200 ng/disk, ii), aggretin (0.6 μg/disk, iii), or compounds in combination with A2-IIE10 (50 μg/mL, iv) or VEGF mAb (1 μg/mL, v-vi) for 48 hours, and then resected, fixed, and photographed with a stereomicroscope at × 10 magnification. A representative one of 3 similar results is shown.
Effect of aggretin on Matrigel capillary tube formation and angiogenesis in the chick CAM model. (A) HUVECs (2 × 105/well) were treated either in the absence (PBS control, i) or in the presence of VEGF (30 ng/mL, iv); in the presence of aggretin (0.1 μM, ii; or 0.3 μM, iii); or preincubated with anti–integrin α2 mAb, A2-IIE10, for 30 minutes, then treated in presence of aggretin (0.1 μM, v), and then plated on diluted Matrigel (4 mg/mL) for 24 hours. After washing and fixation, cells were observed under microscope at × 40 magnification and photographed. A representative one of 4 similar experiments is shown. (B) CAMs of 10-day-old chick embryos were incubated with vehicle (PBS, i), VEGF (200 ng/disk, ii), aggretin (0.6 μg/disk, iii), or compounds in combination with A2-IIE10 (50 μg/mL, iv) or VEGF mAb (1 μg/mL, v-vi) for 48 hours, and then resected, fixed, and photographed with a stereomicroscope at × 10 magnification. A representative one of 3 similar results is shown.
The chick embryo CAM assay is one of the useful models for evaluating angiogenesis.42 In this study, we used this assay to examine in vivo effect of aggretin on the formation of new capillaries. On dissection of the CAMs of 12-day-old chick embryo of either VEGF (200 ng/disk; Figure 2Bii) or aggretin (60 ng/disk; Figure 2Biii) treatment (48 hours), both VEGF and aggretin induced a pronounced neovascularization in the CAM filter disk as compared with that of control (Figure 2Bi). Moreover, aggretin-induced neovascularization in the CAM model was almost abolished in the presence of A2-IIE10 (50 μg/mL; Figure 2Biv) or VEGF mAb (1 μg/mL; Figure 2Bvi). The angiogenic effect induced by VEGF was also blocked by VEGF mAb (1 μg/mL; Figure 2Bv). These inhibitory profiles of integrin α2 and VEGF mAb suggest that integrin α2β1 and VEGF are functional regulators in aggretin-induced angiogenesis.
Binding assays of aggretin toward HUVECs
To study the target site of aggretin on endothelial cells, we first conjugated aggretin and BSA with FITC by a previously described method,43 and examined their binding reactions toward HUVECs by flow cytometry. After incubation of FITC-conjugated aggretin with HUVECs in the presence of Ca2+ (5 mM), the increment of relative fluorescence intensity of the bound FITC-aggretin was concentration dependent and reached a saturated binding at a concentration of 10 μM (Figure 3A). To investigate the aggretin-binding site on HUVECs, a submaximal binding concentration (1 μM) was used in further binding assays. It was noted that mAb A2-IIE10 (50 μg/mL), but not agkistin (50 μg/mL; Figure 3B), inhibited the binding of FITC-aggretin on HUVECs. Moreover, mAb 7E3 raised against integrin αvβ3 showed little effect on the binding reaction of FITC-aggretin toward HUVECs (data not shown). These data indicate that the effect of aggretin on HUVECs may be mediated through interaction with integrin α2β1 but not with GPIb or integrin αvβ3 expressed on HUVECs. As shown in Figure 3C, A2-IIE10 inhibited about 70% inhibition of aggretin binding to HUVECs at 50 μg/mL.
Effect of anti–integrin α2mAb and GPIb antagonist on the binding of FITC-conjugated aggretin to HUVECs. (A) HUVECs (1 × 106 cells) were incubated with various concentrations of FITC-conjugated aggretin or FITC-conjugated BSA for 30 minutes and then analyzed by flow cytometry. Specific binding (⋄) was calculated by subtracting the nonspecific binding (○, as probed by FITC-BSA) from total binding ( , as probed by FITC-aggretin). A representative one of 3 similar results is shown. (B) The binding of FITC-BSA to PBS-treated HUVECs is shown as a dotted line. HUVECs (1 × 106 cells) pretreated with mAb A2-IIE10 (50 μg/mL, thick line) or agkistin (50 μg/mL, thin line) were incubated with FITC-conjugated aggretin (1 μM) and analyzed by flow cytometry. The binding of FITC-aggretin to PBS-treated HUVECs is marked as the gray area. Nonspecific binding was carried out by incubating HUVECs with FITC-conjugated BSA (1 μM). Similar results were obtained in at least 3 separate experiments. (C) Quantitative analyses of FITC-aggretin and FITC-BSA presented as mean fluorescence intensity. Data are presented as mean ± SEM (n = 3). **P < .01 as compared with that of control.
, as probed by FITC-aggretin). A representative one of 3 similar results is shown. (B) The binding of FITC-BSA to PBS-treated HUVECs is shown as a dotted line. HUVECs (1 × 106 cells) pretreated with mAb A2-IIE10 (50 μg/mL, thick line) or agkistin (50 μg/mL, thin line) were incubated with FITC-conjugated aggretin (1 μM) and analyzed by flow cytometry. The binding of FITC-aggretin to PBS-treated HUVECs is marked as the gray area. Nonspecific binding was carried out by incubating HUVECs with FITC-conjugated BSA (1 μM). Similar results were obtained in at least 3 separate experiments. (C) Quantitative analyses of FITC-aggretin and FITC-BSA presented as mean fluorescence intensity. Data are presented as mean ± SEM (n = 3). **P < .01 as compared with that of control.
Effect of anti–integrin α2mAb and GPIb antagonist on the binding of FITC-conjugated aggretin to HUVECs. (A) HUVECs (1 × 106 cells) were incubated with various concentrations of FITC-conjugated aggretin or FITC-conjugated BSA for 30 minutes and then analyzed by flow cytometry. Specific binding (⋄) was calculated by subtracting the nonspecific binding (○, as probed by FITC-BSA) from total binding ( , as probed by FITC-aggretin). A representative one of 3 similar results is shown. (B) The binding of FITC-BSA to PBS-treated HUVECs is shown as a dotted line. HUVECs (1 × 106 cells) pretreated with mAb A2-IIE10 (50 μg/mL, thick line) or agkistin (50 μg/mL, thin line) were incubated with FITC-conjugated aggretin (1 μM) and analyzed by flow cytometry. The binding of FITC-aggretin to PBS-treated HUVECs is marked as the gray area. Nonspecific binding was carried out by incubating HUVECs with FITC-conjugated BSA (1 μM). Similar results were obtained in at least 3 separate experiments. (C) Quantitative analyses of FITC-aggretin and FITC-BSA presented as mean fluorescence intensity. Data are presented as mean ± SEM (n = 3). **P < .01 as compared with that of control.
, as probed by FITC-aggretin). A representative one of 3 similar results is shown. (B) The binding of FITC-BSA to PBS-treated HUVECs is shown as a dotted line. HUVECs (1 × 106 cells) pretreated with mAb A2-IIE10 (50 μg/mL, thick line) or agkistin (50 μg/mL, thin line) were incubated with FITC-conjugated aggretin (1 μM) and analyzed by flow cytometry. The binding of FITC-aggretin to PBS-treated HUVECs is marked as the gray area. Nonspecific binding was carried out by incubating HUVECs with FITC-conjugated BSA (1 μM). Similar results were obtained in at least 3 separate experiments. (C) Quantitative analyses of FITC-aggretin and FITC-BSA presented as mean fluorescence intensity. Data are presented as mean ± SEM (n = 3). **P < .01 as compared with that of control.
Effect of aggretin on HUVEC protein kinase phosphorylation
It is well known that growth factors, ECMs, and tyrosine kinases regulate cell migration and proliferation. Activation of PI3K mediates cell survival and division and participates in regulating cytoskeletal change, such as cell migration. For example, when cells were stimulated by insulin-like growth factor-I (IGF-I), the PI3K activity and p85α tyrosine phosphorylation were increased.44 For elucidating the possible signaling pathways in aggretin-treated endothelial cells, we first examined the effect of aggretin on HUVEC PI3K tyrosine phosphorylation. After incubation of HUVECs with aggretin for various times from 1 minute to 24 hours, the PI3K p85α of cell lysates was immunoprecipitated and then immunoblotted. Figure 4A shows a representative time course of tyrosine phosphorylation of immunoprecipitates from aggretin-treated HUVEC lysates. The phosphorylation of PI3K p85α induced by aggretin (0.1 μM) was significantly elevated in a time-dependent manner. PI3K p85α was transiently phosphorylated within 15 minutes, reaching a peak at 30 minutes and decreasing to near basal levels in 1 hour. After HUVEC exposure to aggretin for 3 hours, PI3K p85α was phosphorylated again and lasted for 24 hours. The aggretin-induced phosphorylation of PI3K was also dose dependent after 30 minutes or 24 hours of treatment (Figure 4B).
Effect of aggretin on PI3K p85α. (A) HUVECs (1 × 106 cells) were cultured in the presence or absence of aggretin (0.1 μM) for various times and then lysed with lysis buffer. After immunoprecipitation (IP) of PI3K p85α, HUVEC lysates were applied to SDS-PAGE (8%). Tyrosine-phosphorylated proteins were detected with Western blotting (WB) using antiphosphotyrosine mAb (4G10) coupled with ECL, and then reprobed with polyclonal antibody (pAb) against PI3K p85α. (B) HUVECs (1 × 106 cells) were cultured in the presence of various concentrations of aggretin for 30 minutes or 24 hours, and then lysed with lysis buffer. Immunoprecipitation and Western blotting were used to measure the tyrosine phosphorylation induced by aggretin, and then reprobing was performed with pAb against PI3K p85α as an internal control. The pattern shown is a representative one of at least 3 similar results.
Effect of aggretin on PI3K p85α. (A) HUVECs (1 × 106 cells) were cultured in the presence or absence of aggretin (0.1 μM) for various times and then lysed with lysis buffer. After immunoprecipitation (IP) of PI3K p85α, HUVEC lysates were applied to SDS-PAGE (8%). Tyrosine-phosphorylated proteins were detected with Western blotting (WB) using antiphosphotyrosine mAb (4G10) coupled with ECL, and then reprobed with polyclonal antibody (pAb) against PI3K p85α. (B) HUVECs (1 × 106 cells) were cultured in the presence of various concentrations of aggretin for 30 minutes or 24 hours, and then lysed with lysis buffer. Immunoprecipitation and Western blotting were used to measure the tyrosine phosphorylation induced by aggretin, and then reprobing was performed with pAb against PI3K p85α as an internal control. The pattern shown is a representative one of at least 3 similar results.
PI3K-mediated activation of serine/threonine kinase Akt is necessary for transmission of cell survival signal triggered by integrin-mediated adhesion. Activation of PI3K leads to the phosphorylation of Akt at Thr308 and Ser473. It is interesting to investigate whether the Akt activation is involved in integrin-α2β1 signaling. As shown in Figure 5A, Akt was activated within 15 minutes after aggretin treatment, and this effect reached a peak in 30 minutes and then decreased in 1 hour. Akt was phosphorylated again after 3 hours and sustained for 24 hours. HUVECs exposed to aggretin (0.01-0.1 μM) showed a concentration-dependent effect in causing Akt phosphorylation in 30 minutes and 24 hours (Figure 5B). These results indicate that the PI3K-signaling pathway may be involved in aggretin-mediated activation of HUVECs in proliferation and migration.
Effect of aggretin on Akt and ERK1/2 phosphorylation. HUVECs (1 × 106 cells) were cultured in the presence of 0.1 μM aggretin for various times, and then lysed with lysis buffer. Akt or ERK1/2 activation was detected by Western blotting (WB) using antiphosphoAkt pAb or antiphosphoERK mAb coupled with ECL, whereas α-tubulin was used as an internal control. The pattern shown is a representative one of at least 3 similar results (A,C). HUVECs (1 × 106 cells) were cultured in the various concentrations of aggretin for 30 minutes or 24 hours and then lysed with lysis buffer and detected with Western blotting using antiphosphoAkt pAb or antiphosphoERK mAb coupled with ECL, whereas α-tubulin was used as an internal control. The pattern shown is a representative one of at least 3 similar results (B,D).
Effect of aggretin on Akt and ERK1/2 phosphorylation. HUVECs (1 × 106 cells) were cultured in the presence of 0.1 μM aggretin for various times, and then lysed with lysis buffer. Akt or ERK1/2 activation was detected by Western blotting (WB) using antiphosphoAkt pAb or antiphosphoERK mAb coupled with ECL, whereas α-tubulin was used as an internal control. The pattern shown is a representative one of at least 3 similar results (A,C). HUVECs (1 × 106 cells) were cultured in the various concentrations of aggretin for 30 minutes or 24 hours and then lysed with lysis buffer and detected with Western blotting using antiphosphoAkt pAb or antiphosphoERK mAb coupled with ECL, whereas α-tubulin was used as an internal control. The pattern shown is a representative one of at least 3 similar results (B,D).
On the other hand, ERK1/2 and FAK are other possible signaling pathways activated by integrin-ligand interaction. It is documented that matrix proteins and growth factors are able to stimulate the ERK phosphorylation in migratory cells.45 ERK1/2 phosphorylation of HUVECs in response to aggretin was clearly detectable by 15 minutes and was maximal at 30 minutes (Figure 5C). The secondary ERK1/2 phosphorylation was observed within 3 hours and decreased at 24 hours. Moreover, after exposure of HUVECs to various concentrations of aggretin (0.01-0.1 μM) for 30 minutes and 24 hours, ERK1/2 phosphorylation was markedly increased in a concentration-dependent manner (Figure 5D).
Activation of integrins by cell exposure to ECMs mostly leads to increases in FAK phosphorylation and enhances cell motility. Therefore, we further tested whether FAK tyrosine phosphorylation is involved in the signaling pathway of aggretin-treated HUVECs. By immunoprecipitation and immunoblotting of aggretin-treated HUVECs, we found that the tyrosine phosphorylation of FAK did not significantly increase even after more than 2 hours of incubation (data not shown). These findings suggest that aggretin-induced HUVEC proliferation may be related to the activation of PI3K/Akt and ERK1/2 pathway but not to FAK phosphorylation.
To determine whether Akt/ERK1/2 activation was dependent on integrin α2β1, HUVECs were pretreated with A2-IIE10 for 30 minutes and then activated by aggretin for various time intervals. The aggretin-induced Akt/ERK1/2 activation was completely abolished after A2-IIE10 treatment, indicating that these signaling transductions were mediated by integrin α2β1 (Figure 6A). Based on the results obtained from the CAM model (Figure 2B), it is deduced that VEGF is involved in aggretin-induced angiogenesis because VEGF mAb blocked aggretin-induced neovascularization. We next attempted to determine the role of VEGF in aggretin-induced signal transduction. HUVECs were pretreated with VEGF mAb for 30 minutes before the addition of aggretin and observed for various time intervals. The primary phase of aggretin in causing ERK1/2 and Akt phosphorylation was not affected as compared to the control, but the secondary delayed phase of aggretin in causing ERK and Akt phosphorylation was reduced (Figure 6B versus Figure 5A,C). These results suggest that VEGF signaling is required for aggretin-induced secondary Akt and ERK activation and the effect may be mediated by VEGF. Next, we investigated whether the VEGF expression is involved in aggretin signaling. The aggretin-treated HUVECs were lysed and assessed by anti-VEGF immunoblotting. After exposure to aggretin, HUVEC lysates showed an increased level of VEGF expression of about 2.5-fold as compared to control at 6 hours, and increased about 5-fold at 24 hours (Figure 6C). The VEGF production induced by aggretin was abolished by A2-IIE10 mAb pretreatment. Because the VEGF produced by HUVECs was in a very low concentration, we used an ELISA kit for the quantitative determination of VEGF in conditioning medium and cell lysates. Aggretin-treated cell lysates showed a significant increase of VEGF in a time-dependent manner and the increased fold was similar to that assayed by ECL (Figure 6D). Thus, the secondary phase of aggretin-stimulated ERK and Akt activation correlated well with the increased VEGF expression.
Effect of anti–integrin α2mAb and VEGF mAb on aggretin-induced Akt and ERK phosphorylation, and VEGF expression by aggretin. HUVECs (1 × 106 cells) were pretreated with anti–α2 integrin mAb, A2-IIE10 (50 μg/mL; A), or VEGF mAb (1 μg/mL; B) for 30 minutes, then cultured in the presence of 0.1 μM aggretin for various times, and then lysed with lysis buffer. Akt and ERK activation was detected with Western blotting using antiphospho-Akt or antiphospho-ERK mAb coupled with ECL, whereas α-tubulin was the internal control. The pattern shown is a representative one of at least 3 similar results. (C) HUVECs (1 × 106 cells) were pretreated with PBS or anti–integrin α2 mAb, A2-IIE10 (50 μg/mL), for 30 minutes, and then cultured in 0.1 μM aggretin for 6 hours or 24 hours. Cells were lysed with lysis buffer and detected with Western blotting using anti-VEGF mAb coupled with ECL, whereas α-tubulin was the internal control. Quantitative analyses of VEGF production were presented as mean density as determined by densitometer. Densitometric band intensities were normalized to static controls, and fold increases were calculated. Data are presented as mean ± SEM (n = 3). *P < .05; **P < .01 as compared with that of control. The pattern shown is a representative one of at least 3 similar results. (D) HUVECs (1 × 106 cells) were cultured in presence or absence (CTL) of 0.1 μM aggretin for 3, 6, or 24 hours. VEGF levels were determined by ELISA, as described in “Materials and methods.” Data are means ± SEM of 3 experiments.
Effect of anti–integrin α2mAb and VEGF mAb on aggretin-induced Akt and ERK phosphorylation, and VEGF expression by aggretin. HUVECs (1 × 106 cells) were pretreated with anti–α2 integrin mAb, A2-IIE10 (50 μg/mL; A), or VEGF mAb (1 μg/mL; B) for 30 minutes, then cultured in the presence of 0.1 μM aggretin for various times, and then lysed with lysis buffer. Akt and ERK activation was detected with Western blotting using antiphospho-Akt or antiphospho-ERK mAb coupled with ECL, whereas α-tubulin was the internal control. The pattern shown is a representative one of at least 3 similar results. (C) HUVECs (1 × 106 cells) were pretreated with PBS or anti–integrin α2 mAb, A2-IIE10 (50 μg/mL), for 30 minutes, and then cultured in 0.1 μM aggretin for 6 hours or 24 hours. Cells were lysed with lysis buffer and detected with Western blotting using anti-VEGF mAb coupled with ECL, whereas α-tubulin was the internal control. Quantitative analyses of VEGF production were presented as mean density as determined by densitometer. Densitometric band intensities were normalized to static controls, and fold increases were calculated. Data are presented as mean ± SEM (n = 3). *P < .05; **P < .01 as compared with that of control. The pattern shown is a representative one of at least 3 similar results. (D) HUVECs (1 × 106 cells) were cultured in presence or absence (CTL) of 0.1 μM aggretin for 3, 6, or 24 hours. VEGF levels were determined by ELISA, as described in “Materials and methods.” Data are means ± SEM of 3 experiments.
Because the cross-regulation of the PI3K/Akt and ERK cascade has been shown to influence proliferation or differentiation of cultured cells,46,47 we analyzed the interaction of Akt and ERK1/2 activation. To analyze whether the activation state of ERK and Akt affect each other, we studied the phosphorylation of these molecules in the absence or presence of a PI3K inhibitor, LY294002, or ERK inhibitor, PD980592. In HUVECs treated with aggretin for 30 minutes and 24 hours, we found that Akt phosphorylation was blocked by LY294002 (10 μM), but not by PD98059 (30 μM; Figure 7A). On the other hand, aggretin-activated ERK1/2 phosphorylation was significantly inhibited by LY294002 as well as by PD98059 after a 30-minute and 24-hour treatment (Figure 7B). These data indicate that PI3K/Akt might play a role upstream in transducing the primary integrin α2β1 and the secondary VEGF-induced ERK activation.
Effect of LY294002 and PD98059 on the phosphorylation of Akt and ERK. (A) Whole cell lysates were prepared from HUVECs (1 × 106 cells) after treatment with PBS, LY294002 (10 μM), or PD98059 (30 μM) in combination with aggretin (0.1 μM) for 30 minutes or 24 hours. Phosphorylated Akt was detected as described in the legend to Figure 6. (B) HUVECs treated with LY294002 (10 μM) or PD98059 (30 μM) in combination with aggretin (0.1 μM) were cultured for 30 minutes or 24 hours and then lysed and subjected to Western blot (WB) analysis with phosphospecific-ERK1/2. The reprobing with anti-α-tubulin antibody was the internal control. The pattern is a representative one of at least 3 similar results.
Effect of LY294002 and PD98059 on the phosphorylation of Akt and ERK. (A) Whole cell lysates were prepared from HUVECs (1 × 106 cells) after treatment with PBS, LY294002 (10 μM), or PD98059 (30 μM) in combination with aggretin (0.1 μM) for 30 minutes or 24 hours. Phosphorylated Akt was detected as described in the legend to Figure 6. (B) HUVECs treated with LY294002 (10 μM) or PD98059 (30 μM) in combination with aggretin (0.1 μM) were cultured for 30 minutes or 24 hours and then lysed and subjected to Western blot (WB) analysis with phosphospecific-ERK1/2. The reprobing with anti-α-tubulin antibody was the internal control. The pattern is a representative one of at least 3 similar results.
Discussion
The development of new blood vessels from preexisting ones is generally referred to as angiogenesis. In the last 3 decades, considerable research has been conducted to document that tumor growth and metastasis require angiogenesis.48 Adhesion molecule receptors expressed on the membrane surface of HUVECs have been well established. Some of them, such as GPIb and integrins αvβ3, αvβ5, and α2β1,11,4 have been implicated in angiogenesis. Because integrins are essentially important for endothelial cell adhesion to ECMs, it is not surprising that they would be involved in anchor-dependent angiogenesis.49 Ligation of integrins induces a cascade of intracellular signals, regulates gene expression, and contributes to mechanisms of proliferation, migration, and differentiation.50 For example, proteolytic cleavage of collagen type IV exposed a hidden regulatory element, and this cryptic site has been shown to promote integrin-ligand interactions required for angiogenesis in vivo.51 Because aggretin has been shown to activate platelets by interacting with integrin α2β1 and GPIb,31 we addressed whether ligation of α2β1 or GPIb affects HUVEC proliferation, migration, or other behaviors. Evidence presented in this study illustrates that aggretin, a member of collagen-like proteins, promotes proliferation and migration (Figure 1), and these effects are blocked by A2-IIE10, a mAb against α2 integrin. Moreover, in the ligand-binding study by flow cytometry, we also demonstrated that aggretin specifically interacts with HUVECs via integrin α2β1, because A2-IIE10 significantly inhibited FITC-conjugated aggretin binding to HUVECs (Figure 3A), whereas 7E3, an αvβ3 mAb, or agkistin, a GPIb antagonist, showed little effect (Figure 3B), suggesting that aggretin promotes angiogenesis mainly through ligation of endothelial α2β1. Consistent with the importance of integrin function during angiogenesis, an antibody that broadly inhibits members of the β1-integrin family has been reported to inhibit development of the embryonic vasculature.52 However, angiogenesis often proceeds in a microenvironment consisting predominantly of interstitial collagens. Although denatured collagen is recognized by αvβ3,53 native collagen is not bound significantly by this integrin. It was reported that α1β1 and α2β1 expression by endothelial cells is an important mechanism by which VEGF promotes angiogenesis and that α1β1 and α2β1 antagonists may prove effective in inhibiting VEGF-derived angiogenesis in cancers and other important pathologies.5,54 Because α1β1 and α2β1 integrins promote cell migration, proliferation, and matrix reorganization, it is reasonable to believe that the activation of α1β1 and α2β1 is involved in angiogenesis. Although integrin α2–null mice do not have any blood vessel abnormality,55 inhibition of integrin α2 expression was reported to result in inhibition of HUVEC tube formation and tumor-induced angiogenesis.56 It is clear that both β1 and αv integrins can support vascular morphogenesis, including α2β1, α5β1, α1β1, α6β1, and αvβ3.57 The involvement of particular integrins is dependent on the matrix environment to which endothelial cells are exposed; both α2β1 and α1β1 integrins regulate endothelial cells morphogenesis in collagen-rich ECMs. The capacity of multiple integrins and matrices to regulate the angiogenic process may be the reason that a single deletion of integrin α2 or collagen permits normal angiogenic development. Owing to the positive results obtained from both in vitro (Matrigel-induced tube formation; Figure 2A) and in vivo (chick CAM model; Figure 2B) angiogenesis assays, results indicate that aggretin does promote capillary formation. The angiogenic-inducing activity of aggretin may be explored as a tool to investigate the involvement of integrin α2β1 in angiogenesis.
In our CAM model and Western blotting experiments, we found that aggretin induced a VEGF-dependent angiogenesis (Figures 2B and 6). We also demonstrated that aggretin stimulated endothelial VEGF expression and this VEGF production effect can be diminished by the anti–integrin α2 mAb, A2-IIE10. It is the first direct evidence of a critical role for the integrin α2β1 activation in regulating VEGF production. In another system, α6β4 integrin regulated VEGF protein expression.58 VEGF is induced by v-Src and by activated Ras,59-62 and both are known to activate PI3K. VEGF has been shown to be induced by the activation of PI3K and Akt in endothelial cells.63 In tumor cells, PI3Kα mRNA and protein expression positively correlated with the expression of VEGF as well as with the extent of microvasculature.64 PI3K inhibitor, LY294002, abrogated VEGF up-regulated by glucose starvation. The signal transduction elicited by α2-integrin ligation of aggretin was shown to activate PI3K and Akt (Figures 4, 5). It is possible that aggretin activates PI3K and Akt, consequently resulting in an increase of VEGF level. On the other hand, it has been reported that Akt directly phosphorylates endothelial nitric oxide synthase (eNOS) and activates the enzyme, leading to NO production.65 Several reports have implicated NO in the angiogenic process.66 Alternatively speaking, aggretin has the ability to activate Akt, and thus may lead to induce VEGF expression. However, it remains to be elucidated.
The signal transduction elicited by α2 integrin ligation is less well understood, due to the lack of a specific agonist for endothelial integrin α2. Therefore, aggretin may be a useful tool to elucidate the integrin α2–mediated signaling pathways in endothelial cells. PI3K is a major signaling molecule involved in cell migration and proliferation. When cells were cultured in the presence of IGF-I, the PI3K activity and p85α tyrosine phosphorylation were increased.44 Similarly, when endothelial cells were treated with aggretin, the tyrosine phosphorylation of PI3K p85α was dramatically increased as compared to serum-free control (Figure 4A). PI3K is activated by integrin engagement and was found to be important in normal fibroblast cell spreading.67 The pathways linking integrin α2 to activation of PI3K are not yet fully defined. The ability of integrins to activate FAK and H-Ras provides 2 potential pathways, because both have been shown to interact with and activate PI3K.68,69 However, the relative contribution of FAK and H-Ras to integrin activation of PI3K is currently unknown. PI3K/Akt/protein kinase B (PKB) is another integrin-mediated cell signaling pathway. In the present study, Akt was activated after aggretin treatment and this effect persisted for at least 24 hours, suggesting that Akt activation may be related to aggretin-induced cell proliferation.
Cell interaction with ECM proteins mediates transmembrane signal transduction including integrin-mediated tyrosine phosphorylation of FAK.70 In our study, FAK tyrosine phosphorylation was not increased by aggretin treatment as compared with that of resting cells (data not shown). Recently, Ivaska et al reported that FAK tyrosine phosphorylation was increased in cells cultured in 3-dimensional collagen gels, but not in monolayer conditions.71 Thus, the reason aggretin did not cause FAK phosphorylation might be related to the monolayer culture system we used in our laboratory. However, in this report, we demonstrated that ERK 1/2 activation is involved in aggretin-induced signaling pathway (Figure 5C). FAK and H-Ras are 2 of the major pathways involved in ERK1/2 activation. In some systems it appears that ERK1/2 and PI3K activation is downstream of FAK activation, whereas in other systems the activation of ERK1/2 and PI3K occurs in the absence of FAK activation.28,72,73 We postulate that HUVECs show robust and persisting ERK1/2 and PI3K activation in response to α2β1 ligation of aggretin, without the involvement of FAK activation.
Our results also indicate that PI3K/Akt plays a positive regulatory role in aggretin-induced HUVEC ERK activation in the initial stage or late phase, because PI3K inhibitor, LY294002, partially inhibited ERK activation in aggretin-treated HUVECs. Recently, the accumulating evidence has suggested that various levels of cross-talk exist between PI3K/Akt and ERK pathways, which may play a role in apoptosis regulation. It has been reported that PI3K may regulate the activity of Rac or mitogen-induced extracellular kinase (MEK) to modulate the Ras/Raf/ERK signaling pathway.46,47 Alternatively, ERK and PI3K/Akt may act as a parallel signaling pathway, and the autocrine or paracrine secretion of growth factor presumably is involved.74,75
In conclusion, results from this report show that aggretin elicits HUVEC proliferation and migration and promotes angiogenesis in vivo and in vitro. According to the flow cytometric binding assay, α2 integrin, but not GPIb or αvβ3 receptor, is the major endothelial-binding site. In addition, aggretin activates integrin α2β1 in promoting VEGF production and angiogenesis. These results have established an association between integrin α2β1 and VEGF production in angiogenesis. Moreover, aggretin stimulates PI3K p85α, Akt, and ERK1/2—but not FAK—phosphorylation in HUVECs, and the increased VEGF production also induces PI3K, Akt, and ERK1/2 activation in HUVECs. The biologic activities of aggretin on human endothelial cells might be explored as a tool to investigate the involvement of integrin α2β1 in angiogenesis. It may be worthwhile to examine whether the angiogenic-promoting activity of aggretin can be used as a therapeutic adjuvant strategy in some ischemia-related diseases.
Prepublished online as Blood First Edition Paper, November 20, 2003; DOI 10.1182/blood-2003-07-2483.
Supported by the National Science Council of Taiwan (NSC 89-2320-B002-257, NSC91-2320-B002-212) and National Health Research Institute (NHRI GT-EX89B920Ls).
The publication costs of this article were defrayed in part by page charge payment. Therefore, and solely to indicate this fact, this article is hereby marked “advertisement” in accordance with 18 U.S.C. section 1734.
We thank Ms L. S. Chao for preparing HUVECs.

, as probed by FITC-aggretin). A representative one of 3 similar results is shown. (B) The binding of FITC-BSA to PBS-treated HUVECs is shown as a dotted line. HUVECs (1 × 106 cells) pretreated with mAb A2-IIE10 (50 μg/mL, thick line) or agkistin (50 μg/mL, thin line) were incubated with FITC-conjugated aggretin (1 μM) and analyzed by flow cytometry. The binding of FITC-aggretin to PBS-treated HUVECs is marked as the gray area. Nonspecific binding was carried out by incubating HUVECs with FITC-conjugated BSA (1 μM). Similar results were obtained in at least 3 separate experiments. (C) Quantitative analyses of FITC-aggretin and FITC-BSA presented as mean fluorescence intensity. Data are presented as mean ± SEM (n = 3). **P < .01 as compared with that of control.
, as probed by FITC-aggretin). A representative one of 3 similar results is shown. (B) The binding of FITC-BSA to PBS-treated HUVECs is shown as a dotted line. HUVECs (1 × 106 cells) pretreated with mAb A2-IIE10 (50 μg/mL, thick line) or agkistin (50 μg/mL, thin line) were incubated with FITC-conjugated aggretin (1 μM) and analyzed by flow cytometry. The binding of FITC-aggretin to PBS-treated HUVECs is marked as the gray area. Nonspecific binding was carried out by incubating HUVECs with FITC-conjugated BSA (1 μM). Similar results were obtained in at least 3 separate experiments. (C) Quantitative analyses of FITC-aggretin and FITC-BSA presented as mean fluorescence intensity. Data are presented as mean ± SEM (n = 3). **P < .01 as compared with that of control.


